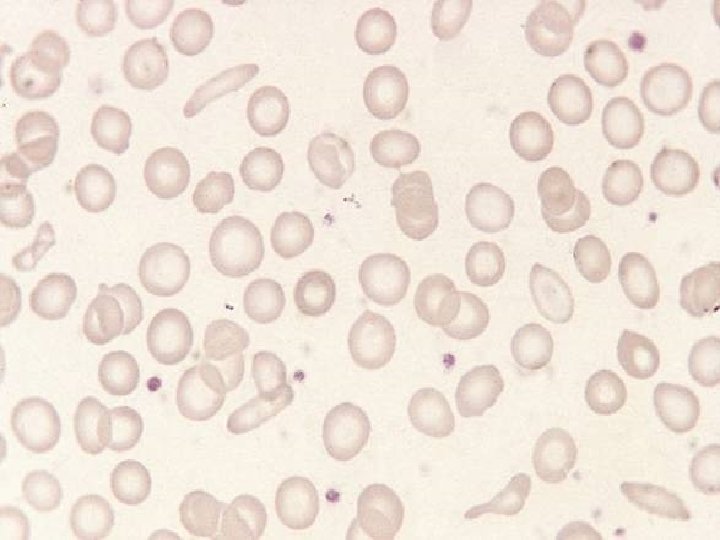
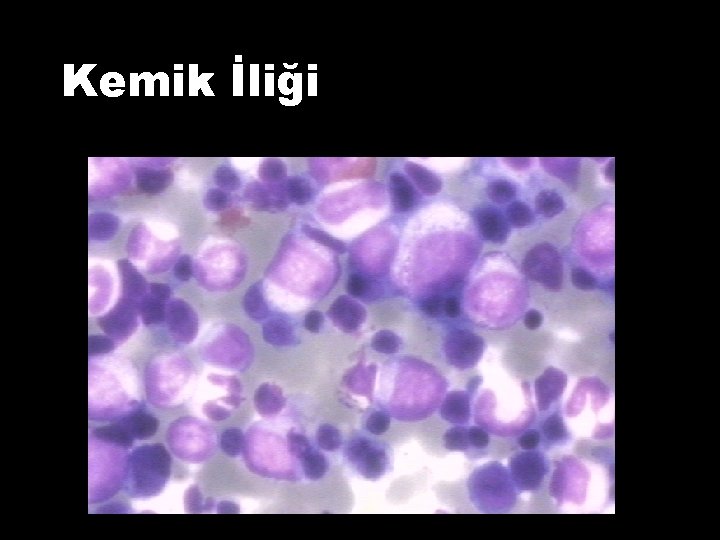
Kemik İliği
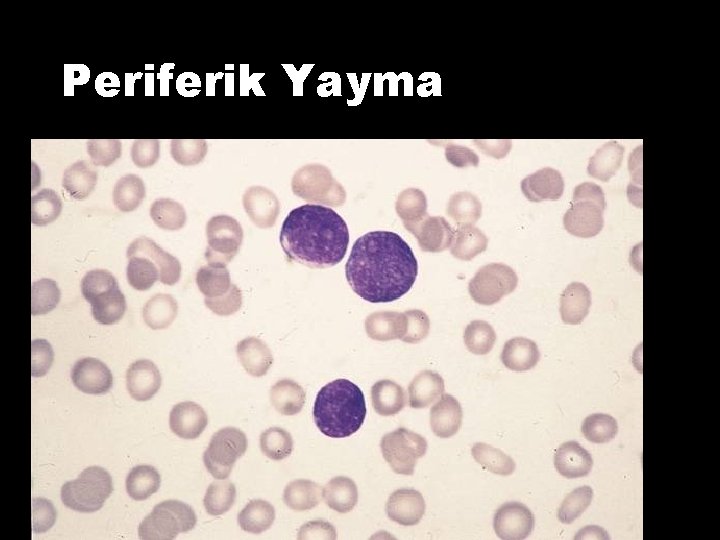
Periferik Yayma

HEPATOSPLENOMEGALi S OLAN OCUA YAKLAIM Do Dr lgen

- Slides: 87
HEPATOSPLENOMEGALi. Sİ OLAN ÇOCUĞA YAKLAŞIM Doç. Dr. İlgen Şaşmaz Sağlık Slaytları İndir http: //hastaneciyiz. blogspot. com
HEPATOMEGALİ
• Çocuklarda hepatomegali primer karaciğer hastalığına bağlı veya sistemik hastalıkların karaciğeri etkilemesi sonucu oluşur. • Doğumda karaciğer vücut ağırlığının %4’ü kadardır.
• Karaciğer büyüklüğünün yenidoğanda 2 -3 cm, 4 -6 ayda <2 cm , daha büyük çocuklarda 1 cm olması normal kabul edilir.
Patofizyoloji’de • • • Hücresel infiltrasyon Glikojen birikimi Lipid birikimi, yağlı infiltrasyon Kupfer hücre hiperplazisi Fibrosis Vasküler konjesyon Kistler Tümörler Abse
Hepatomegali Nedenleri 1. İnfeksiyon ve inflamasyon 2. İnfiltrasyon 3. Depo ve metabolik hastalıklar 4. Extrasellüler matrix genişlemesi 5. Yağlanma 6. Malignite, tümör 7. Vasküler konjesyon 8. Kistik hastalıklar
İnfeksiyon ve inflamasyon I • Viral hepatitler( A-B-C-D-E-G-H, TORCH) CMV, EBV, • Otoimmun hepatit(tip I-II) • Kollajen doku hastalıkları ( SLE, JRA) • Parazitik inf. (şistozomiasis, malaria, visseral larva migrans) • Hepatotoksisite (ilaçlar ve toksinler) • Primer sklerozan kolanjit
İnfeksiyon, inflamasyon II • • • Graft versus host reaksiyonu Bilier atrezi Koledok kistleri Safra yolu striktürü Sistemik granulomatöz hastalıklar(sarkoidoz, tbc) • Hepatik abseler(pyojenik, mikotik)
İnfiltrasyon • Extrameduller hematopoez(eritroblastozis fetalis, hemolitik anemiler) • Metastatik tümörler (nöroblastoma, Wilms tm) • Lösemi • Lenfoma • Histiositik hastalıklar
Depo/ Metabolik hastalıklar • • • Glikojen depo hst Gaucher hst. Nieman Pick Galaktozemi Tirozinemi Wilson hst. Amiloidoz Gangliosidaz Alfa 1 Antitripsin eksikliği
Malignite • Hepatoblastoma • Hepatoselluler karsinoma • Hemanjioma, hemanjiomaendotelyoma
Vasküler Konjesyon • Konjestif kalp hst • Budd-Chiari Send. • Venookluzif Hst.
ÖYKÜ • • • Büyüme gelişme geriliği Karın ağrısı Ateş Diare Nörolojik, psikiatrik bulgular Özel koku Kilo kaybı Kusma Eşlik eden sarılık
Büyüme gelişme geriliği • • • Glikojen depo hastalıkları tip 1 -3 -4 -9 -10 Herediter fruktoz intoleransı Organik asidemiler Wolman hastalığı Kistik fibrozis Hemofagositik lenfohistiositoz
Ateş • • • Akut ve kronik hepatitler Sistemik hastalıklar Hepatik abse Hemofagositik lenfohistiositozis Viral enfeksiyonlar
Anormal koku • Organik asidemiler • Hepatik yetmezlik
Nörolojik ve psikiatrik semptomlar • • • Wilson hastalığı Peroksizomal hastalıklar Lizozomal depo hastalıkları MPS , GM 2 gangliosidoz Porfiri Üre siklüs defektleri İlaç intoksikasyonu Glikolizasyon defektleri Mitokondrial hastalıklar
Fizik muayene • Boyutları belirlemek için palpasyon ve perküsyon beraber yapılmalıdır. • Normalde karaciğer derin inspirasyonda sağ kot kenarından aşağı doğru 1 -3 cm kadar hareket edebilir. • Ksifoidin birkaç cm altına kadar palpe edilebilir. • Palpasyonda düz, keskin sınır, irreguler, nodüler, ağrı
Fizik Muayene • • Asit Splenomegali Koryoretinit Deri lezyonları Subkutan nodüller Lenfadenopati Spider anjioma Depo hastalığına ait bulgular
Eşlik Eden Bulgular • Abdominal kitle Konjenital hepatik fibroz, polikistik böbrek, nöroblastoma, wilms tümörü, hepatoma, hepatoblastoma • Splenomegali konjenital enfeksiyon sistemik enfeksiyon (viral, bakteriyel, fungal) siroz, portal hipertansiyon lenfoma lizozomal depo hastalıkları • Cilt bulguları Kutanöz hemanjiom, telenjektazi, egzematöz döküntü
Eşlik Eden Bulgular • Dismorfik yüz görünümü mukopolisakkaridoz gangliosidoz Gaucher mukolipidozis II Sialidozis alagille sendromu zelweger sendromu • Epizodik akut ensefalopati, koma mitokondrial hastalıklar bazı üre siklüs defektleri yağ asidi oksidasyon defektleri • Malnutrisyon kistik fibrozis
Eşlik Eden Bulgular • Hipotoni Glikojen depo hast Zellweger hast Mitokondrial hast Mukolipidozis • Papuler akrodermatitis Hepatit. B • Göz bulguları Katarakt, Kayser Fleischer • Virilizasyon hepatoblastoma
Eşlik eden bulgular • Karaciğer hassasiyeti akut hepatit konjesyon travma abse kolanjit • Asimetrik hepatomegali tümör kist abse
Laboratuvar • Kan sayımı, periferik yayma • AST, ALT, GGT, ALP, biluribinler, albumin, total protein, kan şekeri, fosfor, CK, amonyak, keton • Koagülasyon testleri • Lipid profili • Hepatit markerları, TORCH • AFP, CEA • Laktik asit, pirüvik asit • İdrar aa, idrar organik asit, aseton • PPD
• AST, ALT artışı hepatosit hasarı (ALT daha spesifik) • Biluribin, safra asitleri, lipid , ALP artışı safra sekresyon bozuklukları • Koagülasyon bozuklukları: Fulminan hepatik yetmezlikte prognozda PT anlamlı • Albumin azalması: KC’de yapımın azalması, malnutrisyon, GIS’den kayıp
• AFP, CEA artışı: Malign neoplazmlar • Lipid, Şilomikronlarda azalma: Son dönem karaciğer hasarı • PY’de vakuollü PNL ve lenfositler Wolman hastalığı, GMI gangliosidoz
• Pansitopeni Hemofagositik lenfohistiositoz, sepsis, lösemi, nöroblastoma, organik asidüri, Schwachman sendromu • Hemolitik anemi Wilson, otoimmun hastalık, hemoglobinopatiler • Hipertrigliseridemi Glikojen depo hastalığı tip I, hemofagositik lenfohistiositozis
• Hipofosfatemi Herediter fruktoz intoleransı, Glikojen depo hst. Tip I • Renal tubuler disfonksiyon tirozinemi tip. I, Wilson, galaktozemi, laktik asidüri • Hiperamonyemi Üre siklüs defektleri, organik asidemi, KC yetmezliği, Reye sendromu, portosistemik şant
Görüntüleme • • ADBG USG, Dopler USG CT MR MR Kolanjiografi Hepatobilier Sintigrafi KC Biyopsisi
ADBG Fokal kitleler, kalsifikasyonlar, subakut abseler, ekinokokal kistler USG Safra kesesi taşları, tümör, kist, abse, hematom, vasküler konjesyon, yağlı infiltrasyonlar KC Biopsisi Kronik viral hepatit, ilaca bağlı KC hst. , otoimmun hepatit, metabolik hst. , malignite, benign lezyonlar, siroz
Diffüz hepatomegali malnutrisyon infiltrasyon Akut yada sistemik hast Venöz konjesyon biyopsi Benign Kist Tümör Teratom Hemanjioma Fokal nodüler hiperplazi metastatik Nöroblastoma Wilms tmörü Lenfoma Lösemi Sarkoma Histiyositpz Prim. malignite Hepatoblastoma HCC Metabolik hast siroz
• • Pulmoner hiperinflasyon Subdiafragmatik abse Pnömotoraks Retroperitoneal abse varlığında karaciğer boyutları normal olmasına rağmen karaciğer aşağı yer değiştirebilir.
SPLENOMEGALİ
Splenomegali birçok hastalığın ortak fiziksel bulgusudur Prematürelerin ve matürlerin %30 ‘u , çocukların %5 -15‘da dalak palpe edilebilir. Dalak fonksiyonlarında bozukluk splenomegali ile sonuçlanır
DALAK FONKSİYONLARI 1. Filtrasyon - eritrosit ve diğer kan hücrelerinin yıkılması - hücre membranının alınması ve yeniden şekillendirilmesi - trombosit, eritrosit, granülosit, demir rezervuarı 2. Hematopoez bölgesi ve kontrolü 3. İmmunolojik fonksiyonlar -dolaşan ve işlenen antijenlerin toplanması -antikor üretiminin uyarılması -lenfosit transformasyon ve çoğalması -makrofaj aktivasyonu
Splenomegali Nedenleri 123456 - İnfeksiyon Hematolojik İnfiltratif Konjestif İmmunolojik Primer dalak hastalıkları
1 -İnfeksiyöz Splenomegali -Bakteriyel: akut ve kronik sistemik enf. , subakut bakt. endokardit, tifoid ateş, milier tbc -Viral: EBV, CMV, HIV Hepatit A-B-C-D-E-G-H -Mantar: Candida, histoplazmozis -Spiroket: sifiliz, Lyme -Protozoal: malaria, toxoplazma, leishmania
2 -) Hematolojik hst: - Hemolitik anemiler( talasemi, SCA, herediter sferositoz), Demir eksikliği anemisi -Extrameduller hematopoez: Osteopetrosis, myelofibrosis -Myeloproliferatif hst. ( polisitemia vera, esansiyel trombositemi
3 -)İnfiltratif Splenomegali -Langerhans hücreli histiositozis -Depo hst. (Gaucher, Nieman Pick, GMI Gangliosidozis, glikojen depo hst. Wolman hst, mukopolisakkoridozlar, amiloidoz, sarkoidoz -Lösemi, lenfoma
4 -) Konjestif Splenomegali -İntrahepatik: siroz( neonatal hepatit, Wilson hst, kistik fibrosis , alfa 1 antitripsin eksikliği) -Prehepatik: portal ven obstruksiyonu(tromboz, vasküler malformasyonlar) -Posthepatik: Budd Chiari send.
5 -)İmmunolojik hst -Serum hst, graft versus hst -Konnektif doku hst(SLE, RA, Sjögren send) -Ortak değişken immun yetmezlik 6 -)Primer dalak hst -Kist -Bening tümör(hemanjiom, lenfanjiom) -Splenik torsiyon, abse
Öykü ü Yenidoğanda umblical kateterizasyon, omphalit ü Geçirilmiş cerrahi ü Abdominal travma ü Ateş ü Kanama Hepatit, CMV, tromboz, PHT splenik hematom, psödokist enfeksiyon, hepatit, EMN, malaria subakut bakteriyel endokardit solukluk, kemik-eklem ağrıları hematolojik malignite
Öykü • Aile hikayesi, etnik köken: Ailede anemi, sık transfüzyon, erken safra taşları, kolesistektomi, splenektomi öyküsü Afrika, Akdeniz kökenliler: talasemi, orak hücre anemisi, G 6 PD Askenazi Yahudileri: Gaucher
Öykü • İlaç alımı: Portal hipertansiyon • Kilo kaybı, anorexi, anormal terleme • Endemik bölgeye ziyaret: malaria, şistozomiasis • • Diare, karın ağrısı Gelişme geriliği Sarılık Yaş
Fizik Muayene • • Dalak boyutları, kıvamı, nodülarite Lenfadenopati Hepatomegali Ekimoz, purpura, solukluk, hemanjiom, infiltratif deri lezyonları • Sarılık • Osler nodülleri, Janeway lezyonları, splinter hemoraji
Fizik Muayene • • • Ateş Üfürüm Distansiyon Artrit, kemik gelişim defektleri Caput medusa, spider anjioma
Eşlik Eden Bulgular • Solukluk: anemi (hemoliz, kemik iliği infiltrasyonu, hipersplenizm) • Peteşi, purpura, ekimoz trombositopeni (otoimmun hst. , hipersplenizm, ki infiltr. , kemik iliği yetmezliği) • Sarılık: hemolitik anemi, KC disfonksiyonu • Döküntü: endokardit akut ve kronik infeksiyon, SLE, RA, infektif • Ateş: akut ise infeksiyon, kronik ise inflamatuar (SLE, RA, sarkoidoz) , malignite (lenfoma, lösemi)
Eşlik eden bulgular. • Üfürüm İnfektif endokardit • Dispne, takipne, ortopne anemi, Langerhans hc. histiositoz, lenfoma(Hodgkin) • Diare salmonella, inflamatuar barsak hst • Karın ağrısı safra taşı , hepatit, travma • Artrit, kemik ağrısı lösemi, nöroblastoma • Gelişme geriliği depo hastalıkları
• Splenomegalinin derecesi: Sol kosta altından 5 cm geçen splenomegali genelde geçici değildir. • Sert ya da nodüler dalak malignensi ya da kronik hemolizi gösterir • Hassas dalak akut büyümeyi ya da infeksiyonu gösterir.
• Akut başlangıçlı splenomegali akut infeksiyon ya da hızla ilerleyen malignansi • Kronik splenomegali hemoliz, depo hastalıkları, konjestif durumlar, inflamasyon
Laboratuvar • Tam kan sayımı, PY, retikülosit • Kan kültürü, viral panel, tuberkülin testi, malaria için kalın damla • Haptoglobulin, biluribinler, ürobilinojen, Coombs, osmotik frajilite • Sedimantasyon • Cu, seruloplazmin • BUN, Cr, albumin, PT, fibrinojen • ANA, RF, C 3, C 4, Ig düzeyleri
Diğer tetkikler • • Batın USG Doppler USG Endoskopi KİA Lenf nodu biopsisi CT, MR Hepatobilier sintigrafi Enzim tayini
• Hemoliz: CBC, PY, retikulosit, biluribin, Coombs, osmotik frajilite, Hb elektroforezi • İnfeksiyon: CBC, kan kültürü, viral panel(EBV, CMV, HIV, toxo, ), tuberkulin, malaria testleri • Karaciğer hast: SGOT, SGPT, albumin, Cu, seruloplazmin,
• Portal HT: SGOT, SGPT, albumin, Protrombin zamanı, USG • İmmunolojik ve inflamatuar hastalık: ESR, C 3, C 4, ANA, RF, BUN, Cr, Ig düzeyleri • İnfiltratif hastalık: KİA, CT, Gaucher için enzim çalışması, depo hst için testler
Splenomegali varlığında • Öykü+ Fizik muayene+ Laboratuar • Hastalığın derecesini belirle • Hafif: Viral enf araştır • Orta ve ağır: sorgula 4 -8 hf takip Hematolojik hastalık bulgularını • Hematolojik hst bulguları varsa, Hemolitik anemi, Extrameduller hematopoez araştır.
Splenomegali ( Hematolojik hastalık bulgusu yoksa ) Akut enfeksiyon bulgusu var Kan kült yok Portal konjesyon bulgusu malaria monospot var yok Sistemik hastalık USG splenoportografi Var KKY BC sendromu PHT(intra) Prehepatik obs Travmatik hematom Kollogen vask h. Depo hast. Metabolik h Benign lezyon Kist Hemanjiom lenfanjiom USG CT yok Kemik iliği biyopsi Lenf nodu biyopsi Karaciğer biyopsi Malign lezyon Lenfoma histiyositoz
Olgu I • 3, 5 yaş , kız • Şikayet: Solukluk, iştahsızlık ve halsizlik • Fizik muayene: Solukluk ve taşikardi, 2 cm splenomegali • Tam kan incelemesi: • Hb: 8. 6 g/d. L Hct: % 24. 8 • MCV: 63. 6 fl MCH: 22. 8 pg • MCHC: 32. 6 g/d. L RDW: % 18. 2 • WBC: 11 200/mm 3 • Plt: 620 000/mm 3
• Ön tanı? • İstenecek tetkikler?
• Tanı: Fe eksikliği anemisi
OLGU II • 6 aylık, erkek hasta • Şikayet: ateş, solukluk • Saptanan Anormal Lab Değerleri: başvurduğu hastaneden anemi ve lökositoz (85700/mm 3) nedeniyle sevk edilmiş • Fizik Muayene: Taşikardik, CVS muayenesinde 2/6 sistolik üfürüm, batın muayenesinde midklavikular hatta karaciğer 9 cm, dalak 8 cm palpabl
Laboratuar • Tam kan incelemesi -Hb: 5. 4 g/dl Hct: %16 -MCV: 60 fl MCH: 21 pg -Ret: %6. 7 -WBC: 111900/mm 3 -Plt: 587. 000 /mm 3
Periferik Yayma
Kemik İliği
Hematolojik Diğer Tetkikler • Hb Elektroforezi: -Hb A: % 21 Hb F: % 74 Hb A 2: % 4, 1 -Anne Hb: 10, 7 g/dl, MCV: 63, Hb A 2: % 4, 5 -Baba Hb: 11 g/dl, MCV: 64, Hb A 2: % 4, 2
• Tanı: Talasemi Major
OLGU III • 4 yaşında, erkek • Şikayeti: Boynunda şişlik • Öykü: 1 hafta önce şişlik oluşmuş ve giderek büyümüş • Boyunda kitle nedeniyle sevkedilmiş
• FM: Genel durumu iyi • Servikal bölgede 2 cm LAP (+) • Karaciğer midklaviküler hatta 1 cm, dalak midklaviküler hatta 6 cm palpabl. • Hb: 11 g/d. L Hct: % 33 • WBC: 19000/mm 3 Plt: 247000/mm 3
PY
• Ön tanı? • Hangi tetkikleri istersiniz?
• Tanı: Enfeksiyöz Mononukleoz
OLGU IV • 2 yaşında, kız • Şikayet: Öksürük ve burun akıntısı • Öykü: 1 aydır bu şikayetler mevcut. Verilen ilaçlarla düzelmemiş • WBC: 65000/ mm 3 saptanarak sevk edilmiş.
• Servikal LAP’ leri mevcut • Karaciğer midklaviküler hatta 6 cm, dalak midklaviküler hatta 3 cm palpabl • Hb: 6, 6 g/d. L Hct: % 18 WBC: 74000/mm 3 Plt: 34 000/mm 3 • FM: Genel durumu iyi
Periferik Yayma
• Ön tanı? • Hangi tetkikleri istersiniz ?
Kemik İliği
• Tanı: ALL-LI
OLGU V • 8 yaşında , erkek • Şikayeti: Ateş, halsizlik, solukluk • Öykü: 3 aydır bu şikayetleri mevcut. • Başvurduğu kurumlarda kanının düşük olduğu söylenerek sevk edilmiş
• Karaciğer midklaviküler hatta 6 cm, dalak midklaviküler hatta 9 cm palpabl. • Hb: 3, 6 g/d. L Hct: • WBC: 3300/mm 3 Plt: 16000/mm 3 % 14
PY
• Ön tanı? • Hangi tetkikleri istersiniz?
• Tanı: Kala-Azar
OLGU VI • 8 yaşında kız hasta • Karın şişliği, karın ağrısı şikayetiyle başvurdu • FM’de karaciğer 5 cm, dalak inguinale uzanıyordu • Laboratuarda: Hct: 25% WBC: 5500 Plt: 150. 000
• Hangi tetkikleri istersiniz? • Ön tanı?
• Kemik iliği aspirasyonu ve biopsisinde köpük hücreler • Tanı: Gaucher hastalığı Sağlık Slaytları İndir http: //hastaneciyiz. blogspot. com